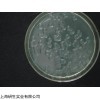
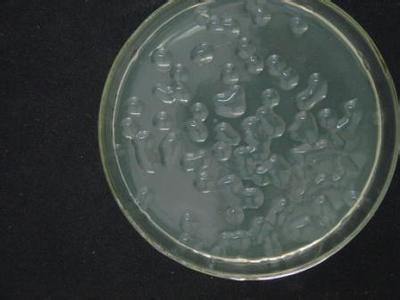

公司承诺
灭蚊链霉菌图片如有质量问题包退换(非人为因素),我们提供价格、用途、配制方法、实验注意事项等一系列详细信息。
中文名称
灭蚊链霉菌图片
属名 Streptomyces
种名加词 culicidicus
收藏时间 2003-8-1
原始编号 ATCC41132
模式菌株 非模式菌株
灭蚊链霉菌图片主要用途 a:1:{i:0;s:4:研究;}
特征特性 孢子丝直,孢子长圆形至柱形,表面光滑。蔗糖硝酸盐琼脂:不生长。克氏合成1号琼脂:气丝绒状,浅粉灰色、浅褐灰色。基丝巧克力棕色。可溶色素初软木黄色,后落叶棕色。葡糖天冬素琼脂:气丝绒状,浅粉灰色、浅褐灰色。基丝中红灰色,后淡咖啡色。可溶色素淡黄色至软木黄色。高氏合成1号琼脂:气丝绒状,浅粉灰色、浅褐灰色。基丝暗驼棕色至中灰驼色。可溶色素玳瑁黄色,后椰壳棕色。葡萄糖酵母膏琼脂:气丝薄,暗灰色至黄灰色。基丝深棕褐色至褐黑色。可溶色素深棕褐色至暗驼棕色。马铃薯块:气丝少,浅灰微黄色。基丝深褐色至黑色,薯块芒果棕色。可溶色素柞叶棕色。明胶液化,黑褐色类。牛奶凝固,后胨化。淀粉水解弱。纤维素上不生长。产生类黑色素。利用葡萄糖、L-阿拉伯糖、D-甘露醇良好;利用D-果糖、棉子糖较差;不利用木糖蔗糖、L-鼠李糖、肌醇。
具体用途 杀蚊虫幼虫
生物危害程度 四类
 灭蚊链霉菌图片
灭蚊链霉菌图片的清洗方法:
1、新购的玻璃器皿
除去包装沾染的污垢后,先用热肥皂水刷洗,流水冲净,再浸泡于1~2%的工业盐酸中数小时,使游离的碱性物质除去,再以流水冲净。对容量较大的器皿,如大烧瓶、量筒等,洗净后注入浓盐酸少许,转动容器使其内部表面均沾有盐酸,数分钟后倾去盐酸,再以流水冲净,倒置于洗涤架上将水空干,即可使用。
2、用过的玻璃器皿
凡确无病原菌或未被带菌物污染的器皿,使用后可随时冲洗,吸取过化学试剂的吸管,可先浸泡于清水中,待到一定数量后再集中进行清洗。有可能被病原菌污染的器皿,必须经过适当消毒后,将污垢除去,用皂液洗刷,再用流水冲洗干净。若用皂液未能洗净的器皿,可用洗液浸泡适当时间后再用清水洗净。洗液的主要成份是重铬酸钾和浓流酸,其作用是将有机物氧化成可溶性物质,以便冲洗。洗液有很强的腐蚀作用,使用时应特别小心,避免溅到衣服、身体和其他物品上。
【注意事项】:由于液体培养基不易长期保管,现在均改制成粉末。
贮存方法:培养基由于配制的原料不同,使用要求不同,而贮存保管方面也稍有不同。一般培养基在受热、吸潮后,易被细菌污染或分解变质,因此一般培养基必须防潮、避光、阴凉处保存。对一些需严格灭菌的培养基(如组织培养基),较长时间的贮存,必须放在2~6℃的冰箱内。由于液体培养基不易长期保管,现在均改制成粉末。营养培养基是在基础培养基中添加一些其它营养物质,如葡萄糖、血液、血清、酵母浸膏等,可供营养要求较高的细菌生长,常用的有血液琼脂斜面及平板。
灭蚊链霉菌图片的是:
1.供货及时。我们订货周期短,运输时间短,在短时间内为您提供所需产品。
2.价格优惠:我公司是ScienCell和美国ATCC的代理商,没有中间环节。在我们保证价格zui低。
3.服务保障:我们拥有专用的技术指导团队,对每售出的一件产品,提供的售前、售中和售后服务。
4.产品种类齐全:25个系统共150多种细胞,满足不同客户的要求。细胞经过严格的质控,纯度可达98%。常用产品备有现货。其产品类型如下:消化系统细胞株,呼吸系统细胞株,泌尿系统细胞株生殖系统细胞株 血液循环系统 内皮细胞细胞株 神经系统及其他细胞株,动物细胞株和菌
5.对于部分难培养的细胞我公司可代复苏细胞,并提供技术支持。
6.经验丰富:我公司是专业化的细胞销售公司,具有十余年细胞产品销售经验,有专业的销售团队和技术人员。
小鼠白细胞分化抗原30(CD30)ELISA Kit,48T/96T
大鼠白细胞分化抗原30(CD30)ELISA Kit,48T/96T
人睫状神经营养因子(CNTF)ELISA Kit,48T/96T
小鼠睫状神经营养因子(CNTF)ELISA Kit,48T/96T
大鼠睫状神经营养因子(CNTF)ELISA Kit,48T/96T
鸡可溶性血管内皮细胞蛋白C受体(sEPCR)ELISA Kit,48T/96T
人可溶性血管内皮细胞蛋白C受体(sEPCR)ELISA Kit,48T/96T
小鼠可溶性血管内皮细胞蛋白C受体(sEPCR)ELISA Kit,48T/96T
大鼠可溶性血管内皮细胞蛋白C受体(sEPCR)ELISA Kit,48T/96T
兔子可溶性血管内皮细胞蛋白C受体(sEPCR)ELISA Kit,48T/96T
鸡1,3-βD葡葡糖苷酶(1,3-βD glucosidase)ELISA Kit,48T/96T
人1,3-βD葡葡糖苷酶(1,3-βD glucosidase)ELISA Kit,48T/96T
小鼠1,3-βD葡葡糖苷酶(1,3-βD glu)ELISA Kit,48T/96T
大鼠1,3-βD葡葡糖苷酶(1,3-βD glu)ELISA Kit,48T/96T
人内分泌腺来源的血管内皮生长因子(EG-VEGF)ELISA Kit,48T/96T
小鼠内分泌腺来源的血管内皮生长因子(EG-VEGF)
大鼠内分泌腺来源的血管内皮生长因子(EG-VEGF)
人鼠嗜酸粒细胞趋化因子(ECF)ELISA Kit,48T/96T
小鼠嗜酸粒细胞趋化因子(ECF)ELISA Kit,48T/96T
大鼠嗜酸粒细胞趋化因子(ECF)ELISA Kit,48T/96T
人嗜酸粒细胞趋化蛋白Eotaxin 1(CCL11)ELISA Kit,48T/96T
小鼠嗜酸粒细胞趋化蛋白Eotaxin 1(CCL11)ELISA Kit,48T/96T
大鼠嗜酸粒细胞趋化蛋白Eotaxin 1(CCL11)ELISA Kit,48T/96T
人红细胞生成素受体(EPOR)ELISA Kit,48T/96T
小鼠红细胞生成素受体(EPOR)ELISA Kit,48T/96T
8-OHdG 8-羟基脱氧鸟苷抗体 0.1ml
RYBP/APAP1/CD337 凋亡相关蛋白1抗体 0.2ml
Nkx2.5/Cardiac-specific homeobox 1 心脏特异性同源盒转录因子NKX2.5抗体 0.2ml
ADORA1 腺苷A1A受体抗体 0.2ml
AMP deaminase 1 腺苷单磷酸脱氨酶1抗体 0.2ml
A2AR/Adenosine A2a receptor 腺苷A2A受体抗体 0.1ml
AACT-Alpha1/A1ACT α-1抗胰糜蛋白酶抗体 0.1ml
AAK1 AP2关联激酶1抗体 0.2ml
Cyp2-j3 细胞色素P450Ⅱj3抗体 0.2ml
OST-beta 有机溶质转运蛋白OSTβ抗体 0.2ml
AANAT 芳香胺N-乙酰化转移酶抗体 0.2ml
AT2R2 血管紧张素Ⅱ受体2抗体 0.2ml
Influenza A virus (Duck) 鸭流感病毒抗体 0.2ml
TNF-alpha 肿瘤坏死因子-α抗体 0.1ml
AARS2 丙氨酰tRNA合成酶2抗体 0.2ml
TDRD9/HIG1 缺氧诱导蛋白HIG1抗体 0.2ml
SIRT1/sirtuin 1 沉默调节蛋白1抗体 0.1ml
Spindly/CCDC99 亚砷盐相关蛋白抗体 0.2ml
TBX-5 转录因子Tbx5抗体 0.1ml
AAT/Tryptase α-1抗胰蛋白酶抗体 0.1ml
AATK AATK细胞凋亡关联酪氨酸激酶抗体 0.2ml
NMP-22 核基质蛋白22 0.1ml
AATF 拮抗凋亡转录因子抗体 0.2ml
灭蚊链霉菌图片ABCA1/ABC1 腺苷三磷酸结合盒转运体A1抗体 0.1ml
ABCD1/CCL22 嗜酸粒细胞趋化蛋白22抗体 0.1ml
ABCB5 ATP结合蛋白家族5抗体 0.1ml
ABCB6 ATP结合蛋白家族6抗体 0.1ml
本页产品地址:http://www.geilan.com/sell/show-7904230.html

![]()
免责声明:以上所展示的[ 灭蚊链霉菌图片]信息由会员[上海研生实业有限公司]自行提供,内容的真实性、准确性和合法性由发布会员负责。
免责声明:以上所展示的[ 灭蚊链霉菌图片]信息由会员[上海研生实业有限公司]自行提供,内容的真实性、准确性和合法性由发布会员负责。